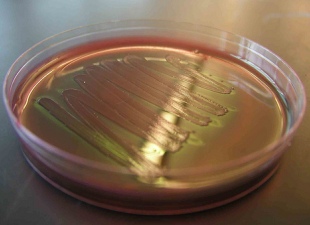

Asian Scientist Newsroom
ABOUT
Asian Scientist Magazine is an award-winning science and technology magazine that highlights R&D news stories from Asia to a global audience. The magazine is published by Singapore-headquartered Wildtype Media Group.
Stories by Asian Scientist Newsroom
Birth Of First Baby Can Trigger Anxiety
Around a third of first-time mothers experience anxiety symptoms after the birth of their baby, a new study has found.
Bats Confirmed As Source Of SARS
Scientists have isolated a very close relative of the SARS coronavirus from bats in China, confirming them as the origin of the pandemic.
BioChain, Epigenomics To Bring Septin9 Screening Technology To China
BioChain and Epigenomics AG have announced a collaboration to bring Epigenomics' Septin9 colorectal cancer screening technology to China.
Bristol-Myers Squibb, Kyowa Hakko Kirin To Commercialize Coniel In China
Bristol-Myers Squibb and Kyowa Hakko Kirin will commercialize Coniel, a calcium channel blocker for the treatment of hypertension and angina pectoris, in China.
3SBio To Develop DJ5 For Progressive Renal Failure
3SBio Inc. has acquired patents for DJ5 to develop DJ5 as a treatment for progressive renal failure in patients with autosomal dominant polycystic kidney disease.
Don’t Miss MIT’s Biggest Technology Conference In Singapore
In January 2014, Singapore will host the inaugural EmTech Singapore, an edition of the world’s most prestigious technology conference for the very first time.
Andrew Holmes Elected President Of The Australian Academy of Science
Organic electronics pioneer Professor Andrew Holmes has been elected as the next President of the Australian Academy of Science.
New Drug Could Ease Pain In Common Bowel Disease
Australian researchers have identified the mechanism of pain relief of a new drug for treating irritable bowel syndrome with constipation.
Oral Bacterial Make Up ‘Ethnic Fingerprint’
New research shows that bacteria in the human mouth are as powerful as a fingerprint at identifying a person’s ethnicity.
Birth Of First Baby Can Trigger Anxiety
Around a third of first-time mothers experience anxiety symptoms after the birth of their baby, a new study has found.
Bats Confirmed As Source Of SARS
Scientists have isolated a very close relative of the SARS coronavirus from bats in China, confirming them as the origin of the pandemic.
BioChain, Epigenomics To Bring Septin9 Screening Technology To China
BioChain and Epigenomics AG have announced a collaboration to bring Epigenomics' Septin9 colorectal cancer screening technology to China.
Bristol-Myers Squibb, Kyowa Hakko Kirin To Commercialize Coniel In China
Bristol-Myers Squibb and Kyowa Hakko Kirin will commercialize Coniel, a calcium channel blocker for the treatment of hypertension and angina pectoris, in China.
3SBio To Develop DJ5 For Progressive Renal Failure
3SBio Inc. has acquired patents for DJ5 to develop DJ5 as a treatment for progressive renal failure in patients with autosomal dominant polycystic kidney disease.
Don’t Miss MIT’s Biggest Technology Conference In Singapore
In January 2014, Singapore will host the inaugural EmTech Singapore, an edition of the world’s most prestigious technology conference for the very first time.
Andrew Holmes Elected President Of The Australian Academy of Science
Organic electronics pioneer Professor Andrew Holmes has been elected as the next President of the Australian Academy of Science.
New Drug Could Ease Pain In Common Bowel Disease
Australian researchers have identified the mechanism of pain relief of a new drug for treating irritable bowel syndrome with constipation.
Oral Bacterial Make Up ‘Ethnic Fingerprint’
New research shows that bacteria in the human mouth are as powerful as a fingerprint at identifying a person’s ethnicity.